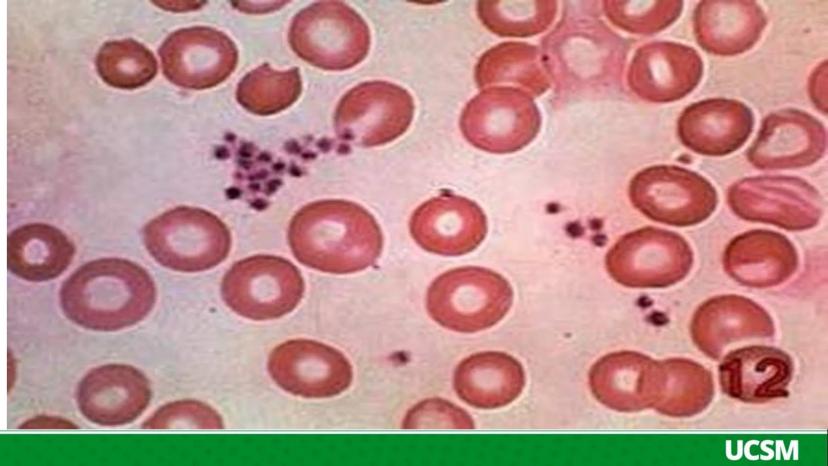
Page 7

¿Alguna vez te has preguntado por qué cuando te cortas,... Mostrar más
Inscríbete para ver los apuntes¡Es gratis!
Acceso a todos los documentos
Mejora tus notas
Únete a millones de estudiantes
Al registrarte aceptas las Condiciones del servicio y la Política de privacidad.